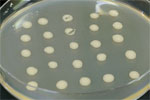

本文
微生物による土壌の浄化技術 国からのお墨付き得て拡販へ
チャンスをつかみ、未来をひらく
Seize a chance and open a bright future.
微生物の力を利用して、油で汚染された土壌の浄化に取り組むゲイト。今年4月には同社の技術が経済産業省と環境省から、両省が設ける「微生物によるバイオレメディエーション利用指針」に適合しているとの承認を受けた。この指針への適合認定は北陸3県では初めてで、全国でも8例目。ベンチャー企業単独としては初の認定である。生態系への影響がなく、環境に優しい工法として国のお墨付きを得たことは、販路開拓に向け、絶好の追い風となりそうだ。
微生物が油を分解。営業中も施工可能
 「バイオレメディエーション」とは微生物などの働きを利用して汚染物質を分解し、土壌や地下水を浄化する技術を指す。経済産業省と環境省の定める指針は、生態系や人の健康に対する安全性の評価や管理手法について示しており、指針への適合はゲイトが展開する土壌浄化事業の安全性、管理法に太鼓判が押されたことを意味する。
「バイオレメディエーション」とは微生物などの働きを利用して汚染物質を分解し、土壌や地下水を浄化する技術を指す。経済産業省と環境省の定める指針は、生態系や人の健康に対する安全性の評価や管理手法について示しており、指針への適合はゲイトが展開する土壌浄化事業の安全性、管理法に太鼓判が押されたことを意味する。
同社が土壌浄化に活用するのは、新潟県胎内市内の油田近くで発見した「GKN-4」など、油を分解する性質を持った数種類の微生物である。ガソリンスタンドや工場の敷地など、油で汚れた土壌に微生物を含んだ液状の製剤を注入すると、微生物が油を水と二酸化炭素に分解し、土壌を元の状態に戻してくれる。
標準的な施工では汚染土1立方メートル当たり1.7kgの製剤を注入する。汚染の度合いによって異なるが、浄化は4 ヵ月から12ヵ月ほどで完了する。微生物は人体にも環境にも無害で、油がなくなると死滅するため、浄化後は残存しない。
これまでは汚染土を掘削、搬出した後、きれいな土で埋め戻す方法が主流だったが、この場合、大量の汚染土を産業廃棄物として埋め立てたり、焼却したりしなければならず、多額の処理費用がかかっていた。この方法に比べるとゲイトの工法は40~60%もコストダウンできるという。
また、ガソリンスタンドや工場が事業を継続しながら施工できる点もメリットの一つだ。土壌の入れ替えは、建物や舗装を取り壊し、更地にした上で施工しなければならないが、ゲイトではボーリング工事によって敷地内に直径10cm、深さ3~5m の穴を開け、そこに管を通して製剤を注入するバイオアドバンテージ工法を確立し、建物や舗装を解体せずに施工できる。
もちろん更地でも施工可能で、この場合、汚染土を重機でかき回しながら製剤を添加するので、より短期間で浄化が完了する。
同社では平成16年から土壌浄化事業に取り組み、これまで全国のガソリンスタンドや工場などで実績を積み上げてきた。同社の山本貴志研究室長は「微生物は目に見えないので中には不安を感じる人もいる。国のお墨付きは今後の取引先拡大に役立つ」と力を込める。
同社では平成16年から土壌浄化事業に取り組み、これまで全国のガソリンスタンドや工場などで実績を積み上げてきた。同社の山本貴志研究室長は「微生物は目に見えないので中には不安を感じる人もいる。国のお墨付きは今後の取引先拡大に役立つ」と力を込める。
ナホトカ号事故を機に環境浄化事業に参入
創業時、書籍や教材の販売を手がけていたゲイトが微生物を使った環境浄化事業に乗り出したのは、平成9年に起きたナホトカ号の重油流出事故がきっかけだった。
 島根県沖で沈没したタンカーからは大量の重油が流出し、石川県の海岸線にも漂着した。このとき、坪内武夫社長をはじめ、ゲイトの社員も清掃ボランティアに参加。しかし、人手が頼りの作業は遅々として進まず、坪内社長は「もっと効率よく油を処理する方法はないか」と思案した。そんな中、坪内社長はボランティアに参加していた大学教授から「自然界には油を分解する微生物がたくさんいる。アメリカでは微生物の力で環境を浄化した事例もある」との情報を耳にする。「この技術を確立して社会貢献したい」。そう考えた坪内社長は同年に環境事業部を立ち上げ、取り組みをスタートさせた。
島根県沖で沈没したタンカーからは大量の重油が流出し、石川県の海岸線にも漂着した。このとき、坪内武夫社長をはじめ、ゲイトの社員も清掃ボランティアに参加。しかし、人手が頼りの作業は遅々として進まず、坪内社長は「もっと効率よく油を処理する方法はないか」と思案した。そんな中、坪内社長はボランティアに参加していた大学教授から「自然界には油を分解する微生物がたくさんいる。アメリカでは微生物の力で環境を浄化した事例もある」との情報を耳にする。「この技術を確立して社会貢献したい」。そう考えた坪内社長は同年に環境事業部を立ち上げ、取り組みをスタートさせた。
当時、微生物による環境浄化の主流となっていたのはアメリカ製の製剤だった。そこに含まれる微生物は外来種であり、どのような微生物がどの程度含まれているのかも明確でない。生態系に悪影響を及ぼす懸念から、重油で汚れた海岸では使えなかった。
そこで、同社では油を分解する国産微生物の採取とそれを培養した製剤の開発に着手。海岸の重油処理には間に合わなかったが、北陸先端科学技術大学院大学などの大学や石川県工業試験場と共同研究を進め、ガソリンや機械油などの鉱物油、サラダ油やラードなどの動植物油を分解する微生物を探し出し、金属加工工場や食品工場の排水処理用などの用途で製品化した。その後、平成14年に土壌汚染対策法が施行され、平成15 年に油汚染対策ガイドラインが策定されるなど、土壌汚染に対する関心の高まりを受け、土壌浄化事業に進出した。
 これまで「微生物によるバイオレメディエーション利用指針」に適合した技術の開発者には大手ゼネコンが名を連ねるが、バイオテクノロジーのノウハウが必要となる分野だけに手の出ないゼネコンも多い。これまでは開発に軸足を置いており、積極的な営業活動はできなかったが、ゲイトでは今後、独自の拡販に加え、こうしたゼネコンとの連携を視野に営業戦略を練っていく。
これまで「微生物によるバイオレメディエーション利用指針」に適合した技術の開発者には大手ゼネコンが名を連ねるが、バイオテクノロジーのノウハウが必要となる分野だけに手の出ないゼネコンも多い。これまでは開発に軸足を置いており、積極的な営業活動はできなかったが、ゲイトでは今後、独自の拡販に加え、こうしたゼネコンとの連携を視野に営業戦略を練っていく。
企業情報
| 企業名 | 株式会社 ゲイト |
|---|---|
| 創業・設立 | 設立 昭和55年4月 |
| 事業内容 | 油分解微生物製剤の開発・製造・販売、土壌・地下水汚染の浄化など |
関連情報
| 関連URL | 関連URLを開く |
|---|---|
| 備考 | 情報誌「ISICO」vol.70より抜粋 |
| 添付ファイル | |
| 掲載号 | vol.70 |






